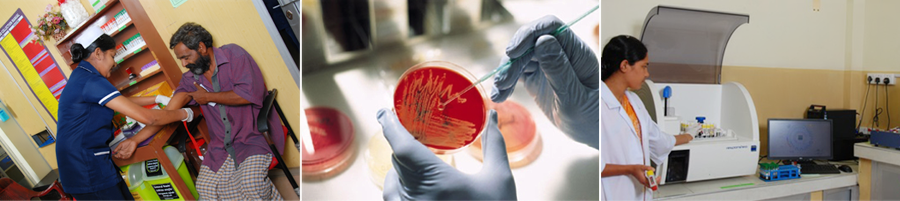

Laboratory Facility
Diagnostics is the cornerstone in the patient care management, so rightly called as the backbone of a hospital. A prompt ANS quality laboratory report will help the clinician in the proper patient management. The Balasooriya hospital laboratory ,which runs 24 hours a day throughout the year.

The laboratory has following areas of services
Patient sample collection area : The sample collection is situated in the ground floor of the outpatient wing. All the out patients report to area for submission of blood, urine and body fluid samples irrespective of the nature of the test. The place comprises of billing counter, blood collection room and a spacious waiting area. also use vacuumised syringes (Vacationer) for the blood collection.

Hematology : The hematology division is equipped with the totally automated blood cell counter with five part differential(NIHON KOHDEN Celtic E)with complete blood count. Anemia, leukemia, bone marrow study, coagulation workup (Hum clot coagulation analyzer)
and reticulocyte count including all hematological investigations are done with stringent quality control. more than 75000 hematological tests done per year. Hematology laboratory supervised by Dr. Thanuja Dissanayake ,MBBS,Dpath,MD-Haematology, FRC-path(UK),Consultant hematologistBiochemistry : Biochemistry division is equipped with modern fully automated biochemistry analyzers (Daisies response 910 fully automated analyzer, Biolytic 2000 ISE electrolyte analyzer)More than 50 different parameters are being analyzed and laboratory performed more than one laky tests per year. This laboratory supervised by a biochemist with consultant pathologist.

Clinical pathology and histopathology : The clinical laboratory and histopathology division is equipped with the automated analyzers (Daisies Star Dust MC 15 clinical chemistry analyzer ,cyon urine chemistry analyzer) and manual techniques also used. All general pathology tests done. Fine needle aspiration biopsy (FNAC),PAP smear ,cytological studies and histopathology tests with special stain techniques done.specially ultra sound guided FNACs routinely done.
This laboratories are supervised by Dr.Anuruddha galappattige ,MBBS,Dpath,MD-Histopathology, Consultant Pathologist.


Microbiology, Serology and parasitological : Clinical microbiology division is specially equipped with culture section. Malarial parasites, micro filarial, Gram's stain ,Acid and alcohol fast bacilli stains and AOC also done. Sample are studied for routine bacterial culture and sensitivity. ASOT ,Rh factor, ANA including all Serological tests done.
This laboratory supervised by Dr. Renuka fernando,MBBS,Dip.(Medical micro),MD(Medical micro),Consultant microbiologist.

Hormone and immunology :
This laboratory equipped with Rocha Eleusis 2010 electrochemiluminescence fully automated hormone, immunology analyser.TSH,T4,T3,FreeT4,FreeT3,FSH,LH,Prolactin,Progesteron,B HCG, Ferreting etc hormonal tests and .HIV, HBsAg, HAV,HCV,VDRL and TPHA, Dengue antibodies and Dengue Antigen test done. This laboratory supervised by a Consultant chemical pathologist
Quality Controls and quality assurance : Our medical laboratory Daily internal quality controls done with standards. Our laboratory is member of RIQAS Randox international quality control assessments scheme -UK, our laboratory is practice of assessing performance in all steps of the laboratory cycle including pre analytical ,analytical and post analytical phases to promote excellent outcomes in medical care. also attuned the aggregate of processes and techniques to detect ,reduce and correct deficiencies in an analytical process. For Quality improvement is the in hospital practice of continuously assessing and adjusting performance using statically and scientifically accepted procedures.
Contact Details | Tel 0323294165/ 032-226-6266 /0322265200/ 0714019149 | Fax : 032-226-6299 | Open 24 hours | 365 days a year
